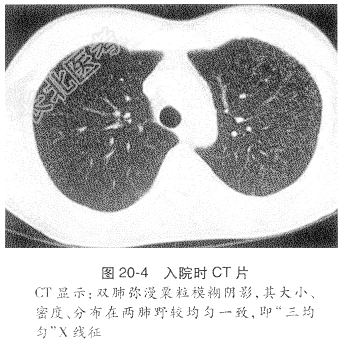

试题详情
- [材料题] 患者,女,23岁。
主诉:间断发热伴头痛半年,咳嗽、胸闷1个月余。
现病史:患者半年前开始出现间断发热、体温38.5℃左右,伴头痛症状,当时无明显恶心、呕吐症状,未予重视。近1个月来上述症状加重,时有恶心、呕吐症状,并出现咳嗽、胸闷、伴乏力、盗汗症状,当地反复抗感染对症治疗1个月无效,胸CT示双肺弥漫粟粒状阴影,进一步脑脊液检查示蛋白1g/L、葡萄糖2.7mmol/L、氯化物115mmol/L、ADA4U/L,头颅MR示颅内多发结节病灶。考虑为急性血行播散性肺结核合并结核性脑膜炎,于2015-5-25始给予抗结核及激素治疗3周余,上述症状无明显好转,为进一步治疗而转我院。自发病以来,食欲缺乏,体重减轻约5kg。
既往体健。
患者入院时查体:体温38.9℃,脉搏110次/min,呼吸23次/min。神志清楚,皮肤、巩膜无黄染,双侧颈部未扪及肿大淋巴结。双肺呼吸运动对称,双肺呼吸音稍粗,未闻及干湿啰音。心率110次/min,律齐,未闻及杂音。腹软,无压痛及反跳痛,肝脾肋下未及,神经系统体征阴性。辅助检查示:血气分析示pH7.45,二氧化碳分压27.9mmHg,氧分压159mmHg,氧饱和度99.3%。血沉35mm/h,C-反应蛋白10mg/L,血结核抗体阴性,血T-SPOT检查A抗原30,B抗原50。血白细胞总数正常。痰浓缩找抗酸杆菌3次阴性,痰荧光双标记定量结核分枝杆菌阴性。血生化示肝肾功能正常。胸CT示双肺弥漫粟粒模糊阴影(图20-4)。腰穿查脑脊液示糖2.9mmol/L、氯化物118mmol/L、ADA1.4U/L、蛋白945mg/L、白细胞5.0×10⁹/L;头颅MR示颅内多发结节空洞样病灶。根据患者以上检查结果诊断为急性血行播散性肺结核;结核性脑膜炎伴颅内多发结核瘤,给予加强抗结核治疗及激素治疗,同时降颅压等对症治疗。待临床症状明显改善后,激素逐渐减量至停用,治疗3个月后复查胸CT示双肺弥漫性病灶基本吸收(图20-5)。复查腰穿查脑脊液化验结果示糖4.0mmol/L、氯化物122mmol/L、ADA1.0U/L、蛋白294mg/L、白细胞5.0较前明显好转。

- 简答题1、血行播散性肺结核可否应用皮质类固醇治疗?什么情况应用?用多长时间?
关注下方微信公众号,搜题查看答案

- 简答题2、血行播散性肺结核的并发症有哪些?
关注下方微信公众号,搜题查看答案

- 简答题3、该疾病对患者的长期生活质量会有哪些影响?如何进行康复指导?
关注下方微信公众号,搜题查看答案

热门试题
- 1、请结合患者的症状、体征及检查结果,阐
- 1、请问经治疗后患者出现烦躁,乱语,应马
- 1、最可能的诊断是?2、应做哪些检查?3
- 1、该患者最可能的诊断是什么?2、该患者
- 1、请阐述该患者结核性脓胸的诊断依据及鉴
- 1、该患者的诊断及依据是?2、该患者如果
- 1、简述结核性脓气胸可能发生的体征。2、
- 1、初步诊断为?2、为明确诊断,应进行的
- 1、该患者的诊断及依据是?2、该患者在治
- 1、该患者的最可能的诊断是?2、辅助检查
- 1、根据患者的临床表现和辅助检查结果,初
- 1、患者可能的诊断及诊断依据是什么?2、
- 1、根据患者的临床表现和辅助检查结果,如
- 1、该患者最可能的诊断是什么?诊断依据有
- 1、患者可能的诊断及诊断依据为2、该病应
- 1、该患者最可能的诊断是什么?2、如果要
- 1、请阐述该患者最可能的诊断及诊断依据。
- 1、本病例最可能的诊断是?2、该病的病因
- 1、请根据该患者的临床表现和辅助检查,分
- 1、请结合患者症状、体征及检查结果,阐述